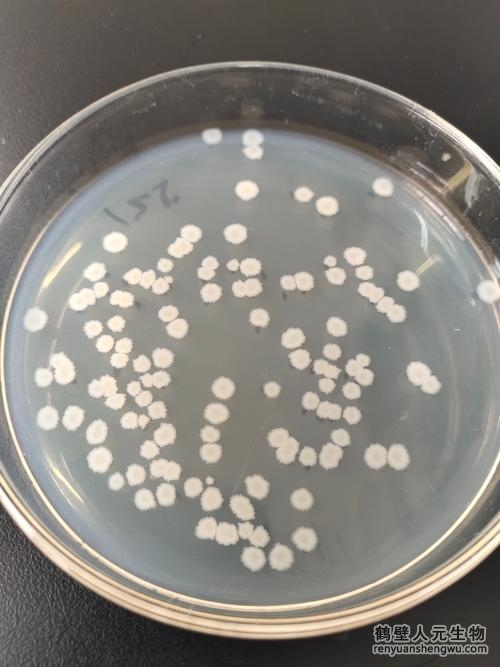

【內(nèi)容摘要】
1、枯草芽孢桿菌能分泌多種抗菌物質(zhì)(如脂肽類抗生素、抑菌蛋白等),可直接抑制或殺滅土壤中的病原菌(如鐮刀菌、根腐病菌、青枯病菌等),減少土傳病害(如枯萎病、根腐病、猝倒?。┑陌l(fā)生。
2、它在土壤中繁殖速度快,能迅速占據(jù)生態(tài)位,與病原菌競爭水分、養(yǎng)分和空間,從而抑制病原菌的生長和擴散。
3、增強植物自身的免疫能力,提高對病害的抵御能力。
1、枯草芽孢桿菌在生長過程中會分泌大量胞外多糖,這些物質(zhì)能黏結(jié)土壤顆粒,促進土壤團粒結(jié)構(gòu)的形成,增強土壤的透氣性、保水性和保肥能力。
2、分解有機質(zhì):能降解土壤中的纖維素、半纖維素等復(fù)雜有機物,將其轉(zhuǎn)化為植物可吸收的小分子營養(yǎng)物質(zhì)(如氨基酸、有機酸等)。
3、溶磷解鉀:通過產(chǎn)生有機酸等物質(zhì),溶解土壤中難溶性的磷、鉀化合物(如磷酸鈣、鉀長石),釋放出有效磷和鉀,提高土壤肥力。
4、固氮作用:部分菌株具有一定的固氮能力,可將空氣中的氮氣轉(zhuǎn)化為植物可利用的氨態(tài)氮,增加土壤氮素含量。

1、枯草芽孢桿菌能產(chǎn)生生長素(如吲哚乙酸)、細胞分裂素等植物生長調(diào)節(jié)物質(zhì),刺激植物根系生長,增強根系對水分和養(yǎng)分的吸收能力,促進植株生長健壯。
2、通過調(diào)節(jié)根際土壤的 pH 值、微生物群落結(jié)構(gòu)等,為植物根系創(chuàng)造適宜的生長環(huán)境,間接促進植物生長。
3、在干旱、鹽堿等逆境條件下,枯草芽孢桿菌可通過提高植物體內(nèi)抗氧化酶活性、積累滲透調(diào)節(jié)物質(zhì)等方式,增強植物的抗逆性。
1、降解有機污染物:能分解土壤中的農(nóng)藥殘留(如有機磷、有機氯農(nóng)藥)、石油烴、多環(huán)芳烴等難降解有機污染物,降低其對土壤和植物的危害。
2、鈍化重金屬:通過吸附、轉(zhuǎn)化等作用,降低土壤中重金屬(如鎘、鉛、汞)的生物有效性,減少其在植物體內(nèi)的積累。
枯草芽孢桿菌通過 “抑菌防病、改良土壤、促生增產(chǎn)、修復(fù)環(huán)境” 等多重作用,成為土壤健康的 “守護者” 和農(nóng)業(yè)可持續(xù)發(fā)展的重要生物資源。在有機肥生產(chǎn)、生物肥料應(yīng)用、土壤改良等領(lǐng)域,其應(yīng)用價值被廣泛認可,是綠色農(nóng)業(yè)中不可或缺的功能微生物。
如果您對“枯草芽孢桿菌在土壤中起到的作用?”還有任何疑問?
歡迎撥打人元有機肥設(shè)備廠家電話:15303928500,或點擊訂購文章中介紹到的設(shè)備。

電話:
15303928500

郵箱:
renyuanshengwu@163.com

地址:
鶴壁市淇濱區(qū)蓮鶴大廈
Copyright ? 2006-2025 鶴壁市人元生物技術(shù)發(fā)展有限公司 版權(quán)所有 丨 備案號:豫ICP備06002949號-1 丨 豫公網(wǎng)安備:41060202000002 丨 360安檢 丨 網(wǎng)站地圖 丨 XML